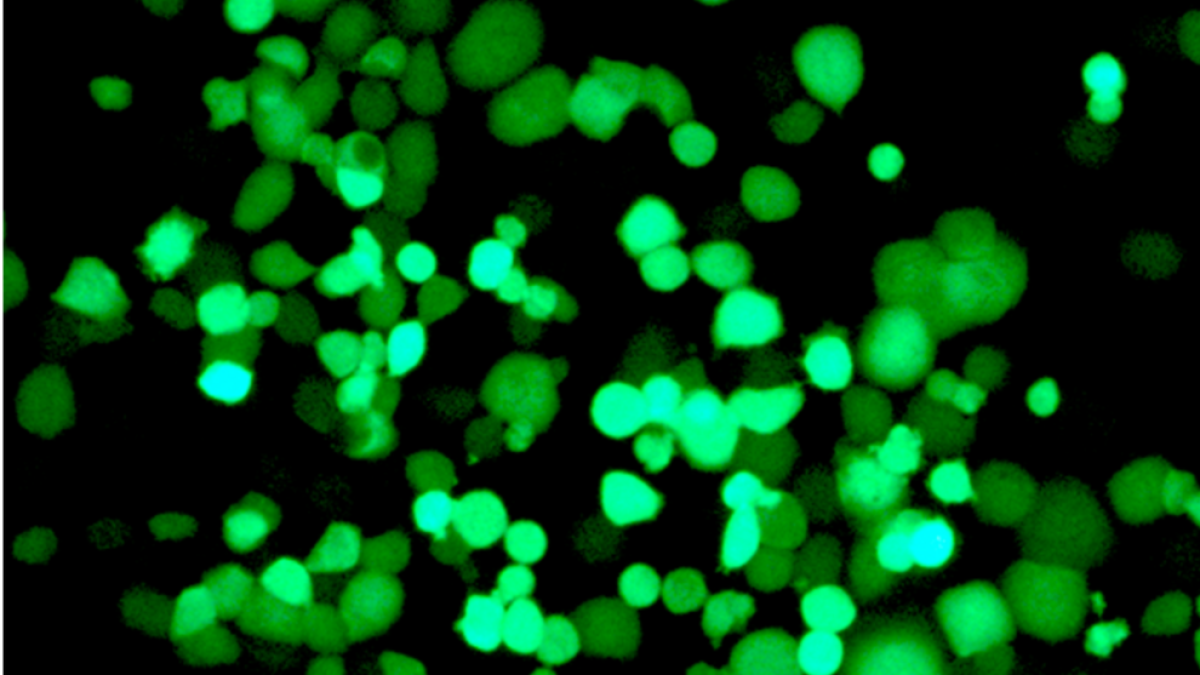
Aconsegueixen crear virus que ataquen de forma selectiva a les cèl·lules tumorals

Investigació mèdica
Aconsegueixen crear virus que ataquen de forma selectiva a les cèl·lules tumorals
El treball ha estat desenvolupat per científics biomèdics a Barcelona
Aconsegueixen crear virus que ataquen de forma selectiva a les cèl·lules tumorals
Científics de l’Institut de Investigaciones Biomédicas August Pi i Sunyer (Idibaps) i de l’Institut d’Investigació Biomèdica (IRB) de Barcelona han aconseguit que virus modificats genèticament ataquin de forma selectiva a les cèl·lules tumorals sense que les sanes es vegin afectades.
El treball, que aquest dijous publica la revista 'Nature Communications', és fruit del treball d’una tesi doctoral d’Eneko Villanueva i l’han coliderat Cristina Fillat, cap del grup teràpia Génica i Càncer de l’Idibaps, i Raúl Méndez, investigador de l’IRB.
Segons ha explicat Méndez, el tractament convencional del càncer pot provocar efectes secundaris no desitjats a causa de la poca selectivitat, i per evitar-los es busquen nous tractaments capaços d’eliminar de forma eficient les cèl·lules cancerígenes i preservar les sanes.
Una de les noves teràpies en càncer es basa en el desenvolupament de virus oncolítics, és a dir, virus modificats perquè només infectin les cèl·lules tumorals.
En els últims anys s’han creat virus amb enginyeria genètica per maximitzar el seu efecte anticancerigen, però a mesura que la potència del virus augmenta, també ho fa la toxicitat associada.
Els investigadors de l’Idibaps i l’IRB han desenvolupat un abordatge innovador per dotar un adenovirus d’una alta especificitat contra les cèl·lules tumorals.
«Hem aprofitat la diferent expressió d’un tipus de proteïnes, les CPEB, en teixits normals i tumorals», ha dit Méndez.
Les CPEB són una família de quatre proteïnes d’unió a l’àcid ribonucleic (ARN) -les molècules que porten la informació dels gens per sintetitzar proteïnes- que controlen l’expressió de centenars de gens i mantenen la funcionalitat i capacitat de reparació dels teixits en condicions normals.
Quan les CPEB es desequilibren, canvien l’expressió d’aquests gens en les cèl·lules i contribueixen al desenvolupament de processos patològics com el càncer.
«Ens hem centrat en el doble desequilibri de dos d’aquestes proteïnes en teixits sans i a tumors: d’una banda tenim CPEB4, que en estudis anteriors demostrem que té una expressió elevada en cèl·lules cancerígenes i que és necessària per al creixement del tumor, i, per l’altre, CPEB1, molt expressada en teixit normal i que es perd en el tumoral», ha afegit Méndez.
«Hem aprofitat aquest desequilibri per fer un virus que només ataca a les cèl·lules amb nivells alts de CPEB4 i baixos de CPEB1, amb la qual cosa només afecta a les cèl·lules tumorals, ignorant les sanes», ha resumit l’investigador.
Fillat ha especificat que en aquesta investigació han treballat amb «adenovirus, una família de virus que poden provocar infeccions respiratòries, de les vies urinàries, conjuntivitis o gastroenteritis, però que posseeixen unes característiques que els fa molt atractius per ser utilitzats com a teràpia davant els tumors».
Per modificar el genoma d’aquest virus, els investigadors van inserir seqüències que reconeixen a les proteïnes CPEB en regions clau per al control de les proteïnes virals, i van comprovar la seua activitat en models d’in-vitro de càncer de pàncrees i van observar un control del creixement del tumor en ratolins.
Els virus oncoselectius creats són molt sofisticats perquè s’activen per a CPEB4, però es reprimeixen per a CPEB1, amb la qual cosa els investigadors van aconseguir una activitat viral atenuada en cèl·lules normals, mentre que en les tumorals es manté o fins i tot augmenta la potència dels virus.
«Quan els virus modificats entren a les cèl·lules tumorals, repliquen el seu genoma i en sortir, destrueixen la cèl·lula alliberant més partícules del virus, capaces d’infectar, al seu torn, a més cèl·lules cancerígenes», ha assenyalat Fillat, que ha subratllat que «aquesta nova aproximació és molt interessant, ja que es tracta d’una teràpia que s’amplifica de forma selectiva al propi tumor».
Ara els investigadors busquen combinar aquest tractament amb teràpies que ja estan a la pràctica clínica o en fases molt avançades de desenvolupament per buscar sinergies i poder ser més eficaços en el control del tumor.